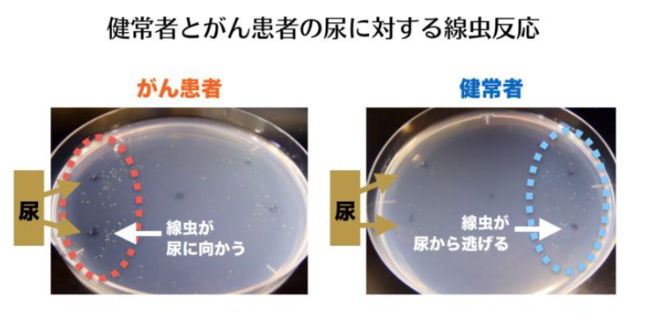

06 22 23 19 怒り イッテq 海底の古代遺跡 という演出に水中考古学者が反論 buzzcut.


ブラック職場で追い詰められた34歳妻が発する 腐った玉ねぎ 体臭とは 医療ジャーナリスト 木原洋美 夫が知らない 妻のココロとカラダの悩み ダイヤモンド オンライン

病気によるにおいを除去して患者さんとご家族の暮らしを改善 治療中の暮らしサポート ケア がん治療 新時代

病気によるにおいを除去して患者さんとご家族の暮らしを改善 治療中の暮らしサポート ケア がん治療 新時代

ストレスに弱いとヤバい 口が臭くなりやすい人 8パターン 口臭で判明 長寿の人 早死する人 president online プレジデントオンライン

病気は匂いでわかる 病気別匂い一覧が話題に ガンは余ったるい匂い むしり取って直ぐの羽毛の匂いとは togetter

dmenuニュース

がんは本当に 臭う のか 特有の臭いを発する病気とは 2015年3月27日 エキサイトニュース

がん検査は 線虫 にお任せ 日経ビジネス電子版

知ってください たばこの害 北海道千歳市公式ホームページ city of chitose

なかなか人に聞けない デリケートゾーンのおはなし スキンケア講座 持田ヘルスケア株式会社

耳が臭い イヤなにおいはどこからやってくるのでしょう 病気スコープ

若い女性特有の いい匂い は10代後半がピーク 維持する方法 ヨミドクター 読売新聞

おならや便がくさいのは 食べ物のせい 大腸の不調

便がドブ臭い これ病気 大腸がんや慢性膵炎のサインかも 病院は何科 medicalook メディカルック

口臭とガン 東京 秋葉原歯医者 原田歯科 歯科 歯科医院 東京都千代田区神田和泉町 秋葉原駅徒歩1分 岩本町駅徒歩5分

甘い臭いやツンとした悪臭は何のサイン 尿の臭いでわかること

子宮体がん 病気について知る 人間ドック 健診会 東京メディカルクリニック

ドッグラボ むこうがおかクリニック 川崎市多摩区登戸 土日も診療

唾液からがんの匂いが明らかに 匂いによる口腔がん診断の技術が確立 歯科スタッフ向けメディアdstyle ディースタイル

今思えば卵巣癌 子宮頸癌の兆候だった症状 抗がん剤治療の体験談 doko様

がん細胞の匂いを嗅ぎ当てる虫がいる 1ミリの 虫 が人類を救う 3 本がすき

子宮頸がんで生じるおりものとは においや色に変化はあるの おりもの以外の症状は メディカルノート
1ミリの線虫が尿の匂いでがん診断 前立腺がんの早期発見の研究開始 j cast ニュース

がん患者入門 入院 手術 お見舞いのタイミング がんを学ぶ ファイザー

化学業界の話題

専門

dog lab 日暮里健診プラザ

hirotsuバイオサイエンス 線虫がん検査に関する世界最先端の線虫行動解析技術

34歳でがんになった 余命3年の写真家が息子に課した 自分の人生を生きる訓練 境界線の越えかた el borde エル ボルデ デキるビジネスパーソンのためのwebマガジン
You May Like